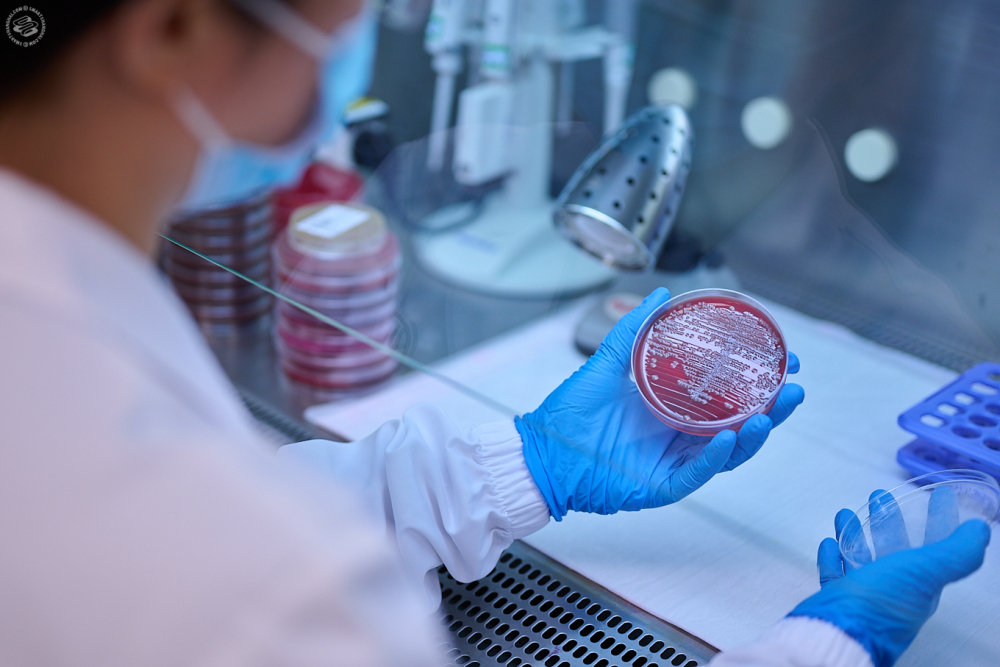
Tomorrow's Doctors and Researchers

Authorized Personnel Only...
Jiahui International Hospital has a well-earned reputation in this city for their stellar, international caliber healthcare services and patient care, forward-thinking, community-minded approach to wellness, and breadth of specialized clinical services, encompassing Jiahui International Cancer Center, Women’s Health, and Orthopedics and Sports Medicine.
It’s… just a really nice hospital... from services to facilities to overall operating ethos.
From overall design to day-to-day operations, everything at Jiahui is organized to be a pristine healing environment, with everything from public spaces to operating theatres constructed around the ideas of safety, security, and efficiency.
Covering an area of almost 40,000 square meters, the 500-bed facility employs a high number of doctors, specialists, and support staff. To get a better idea of how the hospital operates behind the scenes, SmartShanghai took a peek backstage at some of Jiahui’s most interesting support departments.
This is what they're doing behind those "authorization required" doors...